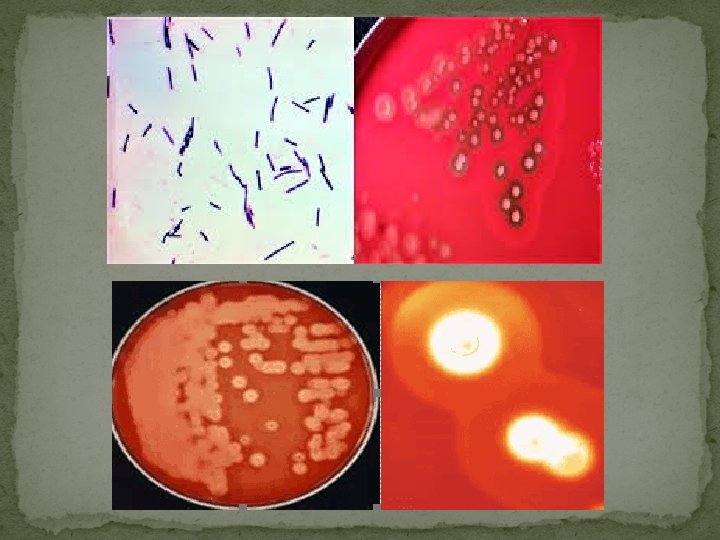

Linstitut Nationale de Formation Suprieur Paramdical MEDEA clostridium

- Slides: 16
L’institut Nationale de Formation Supérieur Paramédical MEDEA clostridium (perfrengenes et septicum)
�Introduction : Le clostridium sont genre de bacilles sporulés, de grande taille, à Gram positif, endosporulés, anaérobies stricts dans leur grande majorité. On les trouve dans le sol, les sédiments aquatiques et dans l'intestin de l'homme et de certains animaux. Leurs spores sont très résistantes à la chaleur, aux radiations et aux agents chimiques Au sein des Clostridium, une classification schématique reposant sur la l'hydrolyse de protéines et la fermentation des glucides est commode pour classer les Clostridium en quatre groupes :
� 1/ C. perfringenes Définition : Clostridium perfringenes (anciennement appelé Clostridium walchii) est un bacille GRAM positif du genre clostridium. La bactérie est immobile, sporulée et anàérobie strict. Cette bactérie va produire des nécrotoxines, provoquant l’entérite nécrosante. Connu comme l'agent des gangrènes gazeuses ou des septicémies du post-partum. Historique : Isolé pour la première fois en 1881, ce germe a vu son rôle dans les gangrènes gazeuses reconnu par Welch, Nuttal et Frankel, puis dans les appendicites aiguës par Veillon. L'étude des facteurs toxiques et la différenciation des types de Clostridium remontent aux années 1950 ; en 1953 Hobbs démontre l'existence d'une entérotoxine. Sources du danger (habitat) : C. perfringens est une bactérie ubiquitaire largement répandue dans l’environnement (sol, sédiments, eaux d’égout, lisiers, cadavres, poussières, surface des végétaux. ). L’Homme et les animaux sains peuvent être porteurs de C. perfringens dans leur tube digestif à hauteur de 10 à 103 bactéries par gramme de contenu. Chez l’animal, C. perfringens peut causer des entérotoxémies, entérites nécrosantes et des gangrènes
�Classification : �Régne : Bacteria �Division : Firmicutes �Classe : Clostridia �Ordre : Clostridiales �Famille : Clostridiaceae �Genre : clostridium
povoire pathogéne : 1. Les infections tissulaires: a/ Infection localisée à la peau et aux tissus mous (tissus souscutanés): infections évoluant lentement et souvent indolentes tels les ulcères de pied, de décubitus. bl Cellulites etfasciites diffuses: Tous les plans superficiels de la peau sont touchés, on retrouve des abcès et la formation de gaz. En l'absence de traitement on observe une extension rapide de la fasciite et un état de choc.
� cl Myonécrose et gangrène gazeuse � - post-traumatiques ou post-chirurgicales survenant entre 8 heures et 20 � � � jours après l'événement initial. - non traumatique après perforation intestinale (néoplasie par exemple). - après avortement septique ou parfois accouchement normal, On peut aussi retrouver C. perfringens dans divers pus, abcès abdominaux, abcès pulmonaires, pleurésies, liquides péritonéaux, avec ou sans signes locaux ou généraux. � � � 2. Les affections digestives � a/ Les toxi-infections alimentaires : � Les symptômes débutent 8 à 12 heures après le repas infectant (viandes notamment) avec crampes abdominales et diarrhée, nausées, fièvre, rarement vomissements. Les troubles diminuent dans les 24 heures. � � bl Entérites nécrosantes : � C'est une affection est rare, il associant diarrhée hémorragique et gangrène spontanée de l'intestin grêle dont le pronostic est sombre.
� Diagnostique : � A - Isolement de C. perfringens : � 1. Prélèvements : � - Hémoculture en anaérobiose. � - Pus qui ont souvent une odeur putride. � - Pièces anatomiques � - la recherche et le dénombrement du germe dans les selles � 2. Examen direct � Cet examen est toujours indispensable sur des pus ou des liquides internes. , il s'agit en effet d'une urgence, qui ne peut attendre, bien souvent, les résultats de la culture. � 3. Cultures � Elles sont effectuées - soit en milieu liquide pour anaérobies avec réducteur ou préalablement régénéré tels que milieu au thioglycolate ou bouillon VF, TGY, PGY, milieu de Rosenow, � - soit en milieu solide, gélose au sang, éventuellement rendue sélective par addition de néomycine (0, 1 %).
� 4. Identification � � Le caractère immobile d'un Clostridium peut déjà orienter vers C. perfringens. Le diagnostic définitif d'espèce repose : � - sur la fermentation du lactose et du saccharose, � - sur la recherche d'une lécithinase, et sur l'inhibition de cette activité enzymatique avec un sérum anti-perfringens A (test de Nagler, de Willis). � Dans un flacon d'hémoculture, le diagnostic de C. perfringens doit être évoqué d'emblée devant le caractère très gazogène, l'hémolyse du sang et sur la visualisation de gros bacilles à Gram positif ; cette constatation doit entraîner une information immédiate d'une suspicion de septicémie à C. perfringens � B - Mise en évidence directe de l'entérotoxine � Elle est effectuée dans les fèces ou dans les aliments dans un contexte d'intoxication alimentaire ; différentes techniques sont proposées : agglutination de particules de latex sensibilisées, électrosynérèse, techniques ELISA. Une sonde oligonucléotidique de synthèse permettant la détection du gène de l'entérotoxine vient d'être utilisée.
�Caractaire chimique : �La protéolyse est, coagulation du lait cystéiné (+) et rapide, indole (-), �uréase (-). � Les glucides sont fermentes avec gaz : glucose, lactose, saccharose, maltose. �Traitement : � Preventif : � Toutes les plaies doivent systématiquement être désinfectées avec des antiseptiques puissants. On doit procéder à l'ablation de tous les corps étrangers et au parage soigneux des plaies. - Une antibioprophylaxie est utilisée en chirurgie
�Curative : � Le traitement repose sur l'usage de la pénicilline G (10 à 50 millions unités/jour), ou l'ampicilline. Certaines céphalosporines sont parfois moins actives. �Prophylaxie : � Les risques concernent essentiellement les préparations à base de viande en sauce. � Respect de la chaîne du froid. � Hygiène générale de préparation des aliments. � Les plats cuisinés doivent être refroidis rapidement après cuisson puis conservés au réfrigérateur (4°C) ou congelés. � Réchauffer rapidement les plats préparés à l’avance.
2/ C. septicum
� Définition : � C. septicum est une grande bactérie gram-positive en forme de bâtonnet qui fait partie de la flore intestinale normale chez l'homme ainsi que chez d'autres animaux. C. septicum sont des formateurs de spores, avec une spore terminale qui donne leur forme de pilon, e sont également des bactéries mobiles, utilisant des flagelles péritriches pour naviguer d'un environnement à l'autre. C. septicum sont des anaérobies fermentaires et peuvent donc vivre d'une variété de substrats comme les sucres, les acides aminés et d'autres composés organiques. � Habitat : � C. septicum est une bactérie résidente de la microflore humaine, mais elle peut être trouvée dans presque tous les habitats anoxiques dans lesquels existent des composés organiques. Dans des conditions défavorables, C. septicum forme des endospores lui permettant de survivre dans des conditions difficiles telles que des températures extrêmes, des terres sèches et des habitats pauvres en nutriments.
� povoire pathogéne : � C. septicum est l'une des nombreuses bactéries responsables de la myonécrose, autrement connue sous le nom de gangrène gazeuse. Les infections sont généralement observées dans les contextes d'immunodéficience, de traumatisme, de chirurgie, de malignité, d'infections / brûlures cutanées et d'avortements septiques. L'un des progéniteurs les plus agressifs de la gangrène gazeuse, l'infection à C. septicum progresse très rapidement, avec un taux de mortalité d'environ 79% chez les adultes, Les symptômes de l'infection comprennent sont : la douleur, décrite comme une lourdeur ou une pression disproportionnée par rapport aux signes physiques, la tachycardie et l'hypotension, nécrose tissulaire provoque alors un œdème et une ischémie entraînant une acidose métabolique, de la fièvre et une insuffisance rénale.
� diagnostique : � le diagnostic soit basé sur des signes de douleur disproportionnés par rapport aux signes cliniques ou aux blessures, une tachycardie marquée, une peau décolorée ou œdémateuse et une tache de gramme de drainage bulleux montrant des bacilles gram positifs sans spores et peu de leucocytes. Les manifestations physiques de l'infection comprennent la douleur causée par l'infiltration du muscle infecté avec œdème et gaz, la tachycardie, la décoloration musculaire et cutanée et la présence d'un écoulement brun et aqueux avec une odeur nauséabonde dans les plaies. � traitement : � Le traitement de l'infection à C. septicum comprend l'administration d'antibiotiques, une intervention chirurgicale et une oxygénothérapie hyperbare (HBOT). Pour la sélection d'antibiotiques, la couverture anaérobie habituelle peut inclure la pénicilline, le métronidazole ou la clindamycine.